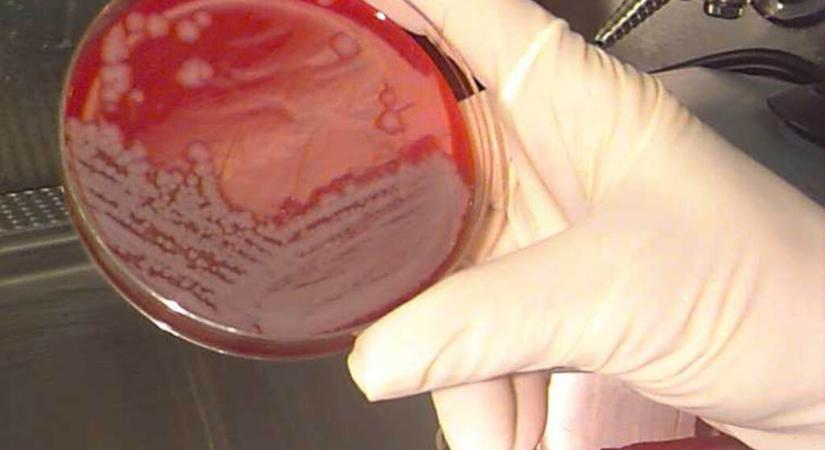
Lépfenét diagnosztizáltak egy páciensnél Magyarországon

Lépfenét diagnosztizáltak egy páciensnél Magyarországon
Egy 70 éves békés vármegyei férfinál igazoltak bőranthrax-megbetegedést, derült ki a Nemzeti Népegészségügyi és Gyógyszerészeti Központ (NNGYK) Járványügyi és Infekciókontroll Főosztályának jelentéséből, ami az október 27. és november 2. között időszakot vizsgálta, írja a Telex. Miután az NNGYK-nak jelezték a gyanút, a járványügyi hatóság azonnal megkezdte a kivizsgálást, majd kiderült, hogy a 70 éves férfi azután […]
- Hirdetés -